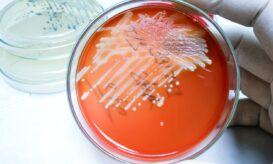
σταφυλόκοκκος

Σταφυλόκοκκος: Πότε μπορεί να προκαλέσει σοβαρές λοιμώξεις – Τα βασικά είδη και τα μέτρα προστασίας
Συνήθως ζει αθόρυβα στο δέρμα και τη μύτη μας. Σε ορισμένες περιπτώσεις όμως μπορεί να προκαλέσει σοβαρές λοιμώξεις που...

Συνήθως ζει αθόρυβα στο δέρμα και τη μύτη μας. Σε ορισμένες περιπτώσεις όμως μπορεί να προκαλέσει σοβαρές λοιμώξεις που...

Πώς μεταδίδεται ο σταφυλόκοκκος, ποια στελέχη είναι πιο επικίνδυνα και πότε μια απλή δερματική λοίμωξη, μπορεί να εξελιχθεί...

Ο σταφυλόκοκκος είναι το βακτήριο που δεν θέλουμε να προσβάλλει τον οργανισμό μας, αλλά κατά πάσα πιθανότητα ήδη το...

Σύμφωνα με τα αποτελέσματα νέας κλινικής μελέτης, ένας νέος τρόπος καταπολέμησης των λοιμώξεων από σταφυλόκοκκο στο αίμα θα μπορούσε...

Το στέλεχος εντοπίστηκε για πρώτη φορά πριν από σχεδόν μια δεκαετία στην Ολλανδία και τη Γερμανία και έκτοτε έχει...
Πώς μπορεί από το δέρμα ή τη μύτη να φτάσει σε όλο το σώμα, προκαλώντας επικίνδυνες επιπλοκές.

Το πρώτο σημάδι που θα εμφανίσει ο σταφυλόκοκκος είναι ένα κόκκινο σημάδι στο δέρμα, το οποίο έχει ζεστή υφή,...

Σταφυλόκοκκος που παράγει τοξίνη ήταν το βακτήριο που απομονώθηκε σε δέκα δείγματα φαγητού, μετά τα συμπτώματα μαζικής δηλητηρίασης που...

Η εργαστηριακή διερεύνηση των γευμάτων για τον εντοπισμό της αιτίας που προκάλεσε τροφική δηλητηρίαση στους μαθητές, έδειξε το μικρόβιο...

Ένα βακτήριο μπορεί να κρατάει το «κλειδί» για την αντιμετώπιση πολλών δερματικών παθήσεων

Η μελέτη περιελάμβανε αναλύσεις του αριθμού, των τύπων και της κατανομής των βακτηρίων στις επιφάνειες του κάθε αντικειμένου.

Ένα από τα πιο επικίνδυνα αντικείμενα γύρω σας είναι πιθανότατα στο χέρι ή στην τσέπη σας αυτή τη στιγμή:...

Τα βακτήρια του σταφυλόκοκκου μπορούν να εξαπλωθούν μέσω μολυσμένων επιφανειών και από άτομο σε άτομο. Τα παιδιά μπορούν να...

Ο σταφυλόκοκκος (Staphylococcus) είναι ένα είδος βακτηρίων που μπορεί να προκαλέσει πολλά είδη λοιμώξεων στο σώμα σας. Πρόκειται για...

Ο σταφυλόκοκκος προκαλείται από το ομώνυμο βακτήριο. Είναι ένας τύπος μικροβίου που υπάρχει με φυσικό τρόπο στο δέρμα, ή...